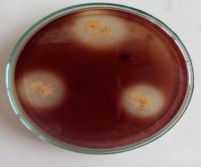
Thủy phân Casein Thủy phân tinh bột – – Phản ứng đồng hóa Citrate Vi 1

TGGGCGAAAGCCTGATCCAGCAATGCCGCGTGCAGGATGAAGGCCTTCGGGTTGTAAA CTGCTTTTGTACGGAACGAAAAAGCTCCTTCTAATACAGGGGGCCCATGACGGTACCG TAAGAATAAGCACCGGCTAACTACGTG CCAGAGCCCGCGGTAAA
Kết quả giải trình tự dòng T2/2 CTGGCTCAGAGTGAACGCTGGCGGTAGGCCTAACACATGCAAGTCGAACGGCAGCAC AGGAGAGCTTGCTCTCTGGGTGGCGAGTGGCGGACGGGTGAGGAATACATCGGAATC TACTCTGTCGTGGGGGATAACGTAGGGAAACTTACGCTAATACCGCATACGACCTACG GGTGAAAGCAGGGGACCTTCGGGCCTTGCGCGATTGAATGAGCCGATGTCGGATTAGC TAGTTGGCGGGGTAAAGGCCCACCAAGGCGACGATCCGTAGCTGGTCTGAGAGGATG ATCAGCCACACTGGAACTGAGACACGGTCCAGACTCCTACGGGAGGCAGCAGTGGGG AATATTGGACAATGGGCGCAAGCCTGATCCAGCCATACCGCGTGGGTGAAGAAGGCC TTCGGGTTGTAAAGCCCTTTTGTTGGGAAAGAAA TCCA
Kết quả giải trình tự dòng T4/1 GATCCTGGCTCAGATTGAACGCTGGCGGCAGGCTTAACACATGCAAGTCGAGCGGAG ATGAGGTGCTTGCACCTTATCTTAGCGGCGGACGGGTGAGTAATGCTTAGGAATCTGC CTATTAGTGGGGGACAACATTCCGAAAGGAATGCTAATACCGCATACGTCCTACGGGA GAAAGCAGGGGATCTTCGGACCTTGCGCTAATAGATGAGCCTAAGTCGGATTAGCTAG TTGGTGGGGTAAAGGCCTACCAAGGCGACGATCTGTAGCGGGTCTGAGAGGATGATCC GCCACACTGGGACTGAGACACGGCCCAGACTCCTACGGGAGGCAGCAGTGGGGAATA TTGGACAATGGGGGAAACCCTGATCCAGCCATGCCGCGTGTGTGAAGAAGGCCTTATG GTTGTAAAGCACTTTAAGCGAGGAGGAGGCTACTGAGACTAATACTCTTGGATAGTGG ACGTTACTCGCAGAATAAGCACCGGCTAA CTCTGTG
Kết quả giải trình tự dòng T1 TTGGAGAGTTTTGATCCTGGCTCAGAGTGAACGCTGGCGGTAGGCCTAACACATGCAA GTCGAACGGCAGCACAGGAGAGCTTGCTCTCTGGGTGGCGAGTGGCGGACGGGTGAG GAATACATCGGAATCTACTCTGTCGTGGGGGATAACGTAGGGAAACTTACGCTAATAC CGCATACGACCTACGGGTGAAAGCAGGGGACCTTCGGGCCTTGCGCGATTGAATGAGC CGATGTCGGATTAGCTAGTTGGCGGGGTAAAGGCCCACCAAGGCGACGATCCGTAGCT GGTCTGAGAGGATGATCAGCCACACTGGAACTGAGACACGGTCCAGACTCCTACGGG AGGCAGCAGTGGGGAATATTGGACAATGGGCGCAAGCCTGATCCAGCCATACCGCGT GGGTGAAGAAGGCCTTCGGGTTGTAAAGCCCTTTTGTTGGGAAAGAAATCCAGCCGGC TAATACCTGGTTGGGATGACGGTACCCAAAGAATAAGCACCGGCTAACTTCGTGCCAG CAGCCCGCGGTAA
Kết quả giải trình tự dòng C2/1 TCAGGATGAACGCTAGCGGGAGGCCTAACACATGCAAGCCGAGCGGTAGAGATCTTT CGGGATCTTGAGAGCGGCGTACGGGTGCGGAACACGTGTGCAACCTGCCTTTATCAGG GGGATAGCCTTTCGAAAGGAAGATTAATACCCCATAATATATTGAGTGGCATCACTTA ATATTGAAAACTCCGGTGGATAGAGATGGGCACGCGCAAGATTAGATAGTTGGTGAG GTAACGGCTCACCAAGTCTGCGATCTTTAGGGGGCCTGAGAGGGTGATCCCCCACACT GGTACTGAGACACGGACCAGACTCCTACGGGAGGCAGCAGTGAGGAATATTGGACAA TGGGTGCGAGCCTGATCCAGCCATCCCGCGTGAAGGACGACGGCCCTATGGGTTGTAA ACTTCTTTTGTATAGGGATAAACCTACTCTCGTGAGAGTAGCTGAAGGTACTATACGA ATAAGCACCGGCTAACTCC
Kết quả giải trình tự dòng C8/1 TGGGGGCCCTTCTTCTGAGGTACCGTCACTTTCGCTTCTTCCCTACTGAAAGAGGTTTA CAACCCGAAGGCCGTCATCCCTCACGCGGCGTCGCTGCATCAGGCTTGCGCCCATTGT GCAATATTCCCCACTGCTGCCTCCCGTAGGAGTCTGGGCCGTGTCTCAGTCCCAGTGTG GCCGGTCACCCTCTCAGGCCGGCTACCCGTCGTCGCCTTGGTGAGCCATTACCTCACCA ACAAGCTGATAGGCCGCGAGTCCATCCCCCACCGATAAATCTTTCAACAACCCACCAT GCAGTAGGAAGTCATATCCGGTATTAGACCCAGTTTCCCGGGCTTATCCCAGAGTCGG GGGCAGGTTACTCACGTGTTACTCACCCGTTCGCCACTAATCCACCCTGCAAGCAGGG
CTTCATCGTTCGACTTGCATGTGTTAAGCACGCCGCCAGCGTTCATCCTGAGCCAGGAA CAAACTCTCTAA.
Kết quả giải trình tự dòng C9/1 GGTGGGGGGGCGTGCCTATACATGCAAGTCGAGCGAACTGATTAGAAGCTTGCTTCTA TGACGTTAGCGGCGGACGGGTGAGTAACACGTGGGCAACCTGCCTGTAAGACTGGGA TAACTTCGGGAAACCGAAGCTAATACCGGATAGGATCTTCTCCTTCATGGGAGATGAT TGAAAGATGGTTTCGGCTATCACTTACAGATGGGCCCGCGGTGCATTAGCTAGTTGGT GAGGTAACGGCTCACCAAGGCAACGATGCATAGCCGACCTGAGAGGGTGATCGGCCA CACTGGGACTGAGACACGGCCCAGACTCCTACGGGAGGCAGCAGTAGGGAATCTTCC GCAATGGACGAAAGTCTGACGGAGCAACGCCGCGTGAGTGATGAAGGCTTTCGGGTC GTAAAACTCTGTTGTTAGGGAAGAACAAGTACGAGAGTAACTGCTCGTACCTTGACGG TACCTAACCAGAAAGCCACGGCTAACTACGTGCCAGCAGCCGCGGGTAATAAAA.
Kết quả giải trình tự dòng T5/3 TCGGGGGGGGGGGTGAAAAAATAATGCAGTCGAGCGAACTGATTAGAAGCTTGCTTC TATGACGTTAGCGGCGGACGGGTGAGTAACACGTGGGCAACCTGCCTGTAAGACTGG GATAACTTCGGGAAACCGAAGCTAATACCGGATAGGATCTTCTCCTTCATGGGAGATG ATTGAAAGATGGTTTCGGCTATCACTTACAGATGGGCCCGCGGTGCATTAGCTAGTTG GTGAGGTAACGGCTCACCAAGGCAACGATGCATAGCCGACCTGAGAGGGTGATCGGC CACACTGGGACTGAGACACGGCCCAGACTCCTACGGGAGGCAGCAGTAGGGAATCTT CCGCAATGGACGAAAGTCTGACGGAGCAACGCCGCGTGAGTGATGAAGGCTTTCGGG TCGTAAAACTCTGTTGTTAGGGAAGAACAAGTACAAGAGTAACTGCTTGTACCTTGAC GGTACCTAACCAGAAAGCCACGGCTAACTACGTGCCAGCAGCCGCGGTAATAAAA
Kết quả giải trình tự dòng C10 AGGGGGGGGCTGCCTATACTGCAAGTCGAGCGCAGGAAGTTATCTGATCCTCTTTTAG AGGTGACGATAATGGAATGAGCGGCGGACGGGTGAGTAACACGTAGGCAACCTGCCT GTAAGACTGGGATAACTCGTGGAAACGCGAGCTAATACCGGATAACACTTTTCATCTC CTGATGAGAAGTTGAAAGGCGGCTTTTGCTGTCACTTACAGATGGGCCTGCGGCGCAT TAGCTAGTTGGTAAGGTAATGGCTTACCAAGGCGACGATGCGTAGCCGACCTGAGAGG GTGATCGGCCACACTGGGACTGAGACACGGCCCAGACTCCTACGGGAGGCAGCAGTA GGGAATCTTCCGCAATGGACGAAAGTCTGACGGAGCAACGCCGCGTGAGTGATGAAG GTTTTCGGATCGTAAAACTCTGTTGTTAGGGAAGAACAAGTGCCATAGTAACTGATGG CACCTTGACGGTACCTAACCAGAAAGCCACGGCTAACTACGTGCCAGCAGCCGCGGTA ATAAA.
Kết quả giải trình tự dòng T7/3 ATGGGCGGCGTGCTTACCATGCAAGTCGAACGATGAAGCCCAGCTTGCTGGGTGGATT AGTGGCGAACGGGTGAGTAACACGTGGGTGATCTGCCCTGCACTTCGGGATAAGCCTG GGAAACTGGGTCTAATACCGGATAGGACCTCGGGATGCATGTTCCGGGGTGGAAAGG TTTTCCGGTGCAGGATGGGCCCGCGGCCTATCAGCTTGTTGGTGGGGTAACGGCCCAC CAAGGCGACGACGGGTAGCCGGCCTGAGAGGGCGACCGGCCACACTGGGACTGAGAC ACGGCCCAGACTCCTACGGGAGGCAGCAGTGGGGAATATTGCACAATGGGCGCAAGC CTGATGCAGCGACGCCGCGTGAGGGATGACGGCCTTCGGGTTGTAAACCTCTTTCAGT ACCGACGAAGCGCAAGTGACGGTAGGTACAGAAGAAGCACCGGCCAACTACGTGCCA GCAGCCGCGGTAAAAAAAGTGACGGTAGGTACAGAAGAAGCACCGGCCAACTACGTG CCAGCAGCCGCGGTAATAA.
Kết quả giải trình tự dòng T9 ACGGGGCGCGGTACTAACCTGCAGTCGAACGATGAAGCCCAGCTTGCTGGGTGGATTA GTGGCGAACGGGTGAGTAACACGTGGGTGATCTGCCCTGCACTTCGGGATAAGCCTGG GAAACTGGGTCTAATACCGGATAGGACCTTCTGCCGCATGGTGGGGGGTGGAAAGGTT TTCCGGTGCAGGATGGGCCCGCGGCCTATCAGCTTGTTGGTGGGGTAACGGCCCACCA AGGCGACGACGGGTAGCCGGCCTGAGAGGGCGACCGGCCACACTGGGACTGAGACAC GGCCCAGACTCCTACGGGAGGCAGCAGTGGGGAATATTGCACAATGGGCGCAAGCCT
GATGCAGCGACGCCGCGTGAGGGATGACGGCCTTCGGGTTGTAAACCTCTTTCAGTAC CGACGAAGCGCAAGTGACGGTAGGTACAGAAGAAGCACCGGCCAACTACGTGCCAGC AGCCGCGGTAATAA.
1.4.4 Kết quả sinh hóa để xác định 2 chủng vi khuẩn C9/1, T5/3 thuộc chi Bacillus sp. ( khóa phân loại Bergey).

Thủy phân Casein Thủy phân tinh bột
+ –
–
+
Phản ứng đồng hóa Citrate Vi khuẩn phát triển ở nồng độ 6,5% NaCl
+
-
Vi khuẩn C3/1 và T1 phát triển ở nồng độ muối 4,5%, 42oC trên môi trường lỏng và môi trường thạch
1.4.5. Kết quả sinh hóa xác định các chủng vi khuẩn TKT, T2/2, C2/2, C4/2, C3/1 và T1
1.4.6 Khảo sát chuyển hóa nitrite của 11 chủng vi khuẩn NOB
Bảng 1.10 Hiệu suất chuyển hóa nitrite của 11 dòng vi khuẩn NOB
Hiệu suất chuyển hóa NO2- (%) | ||||||
12 h | 24 h | 36 h | 48 h | 60 h | 72 h | |
CKT | 16,90d±0,01 | 34,26d±0,01 | 64,87c±0,03 | 89,77bc±0,08 | 94,56bc±0,02 | 96,62abc±0,01 |
C2/1 | 9,80f±0,08 | 34,64cd±0,46 | 64,95c±1,16 | 87,06de±1,14 | 96,86ab±0,67 | 97,99a±0,58 |
C2/2 | 15,53d±0,58 | 24,67e±0,27 | 61,90d±0,58 | 87,94cd±0,57 | 96,16ab±0,57 | 96,16abc±0,58 |
C3/1 | 9,52f±0,06 | 19,96f±0,57 | 56,64e ±0,57 | 83,10fg ±0,46 | 90,76e±0,58 | 95,31bc±0,60 |
C4/2 | 12,25e±0,69 | 26,54e±0,57 | 60,34d±0,66 | 85,07ef±0,53 | 91,65de±0,57 | 95,15bc±0,57 |
Có thể bạn quan tâm!
-
Khảo Sát Hàm Lượng Mật Rỉ Của P. Stutzeri Kl15 33 -
Phân Lập, Định Danh Vi Khuẩn Bacillus Và Khảo Sát Khả Năng Chuyển Hóa Ammonia Của Các Dòng Vi Khuẩn Bacillus -
Hình Ảnh Tra Phần Mềm Phản Ứng Sinh Hóa Của Nhóm Vi Khuẩn Aob/nob -
Đường Tuyến Tính Mật Số Vi Sinh Vật Với Od600Nm -
Một Số Hình Ảnh Của Lên Men Vi Sinh Vật Dạng Lỏng Và Bột. -
Hàm Lượng Tan Trong Thời Gian 30 Ngày Thử Nghiệm Tôm Ở Bể
Xem toàn bộ 247 trang tài liệu này.
27,73b±0,57 | 35,58cd±1,15 | 74,86b±0,57 | 89,19bcd±0,48 | 93,58cd±0,81 | 95,73bc±0,58 | |
T1 | 13,14e±0,48 | 25,59e±0,21 | 56,25e±0,57 | 82,07g±0,38 | 92,90cde±0,27 | 95,05c±0,60 |
T2/2 | 21,39c±0,68 | 64,86a±0,57 | 80,73a±1,17 | 94,76a±0,58 | 97,52a±0,23 | 98,21a±0,46 |
T3/1 | 31,97a±0,06 | 36,57c±0,06 | 81,19a±0,05 | 94,30a±0,35 | 96,60ab±0,57 | 97,29ab±0,23 |
T4/1 | 17,96d±0,58 | 52,52b±0,06 | 76,17b±0,46 | 91,41b±0,29 | 93,91bc±0,57 | 96,18abc±0,17 |
T9 | 45,51a±0,75 | 69,84a ±1,5 | 77,52b ± 0,1 | 82,63fg±1,4 | 89,84f± 0,61 | 95,01bc±0,6 |
Trong cùng một cột, các giá trị có ký tự theo sau giống nhau không có sự khác biệt về mặt thống kê (P < 0,05).
1.5. Xây dựng đường chuẩn ammonia, nitrite, nitrate
Hình 1.13 Đường chuẩn nitrite |

Hình 1.14 Đường chuẩn nitrate
Phương pháp phân tích ammonia (PHENAT)
Dung dịch phenol: trộn 11,1 ml phenol (≥ 89%) với rượu etylic (95%) đến 100 ml. Pha dung dịch hàng tuần.
Dung dịch natri nitroprusit: hòa tan 0,5 g natri nitroprusit trong nước cất và định mức đến 100 ml. Bảo quản trong chai màu hổ phách hay nâu.
Dung dịch citrate: hòa tan 200 g natri citrate và 10 g NaOH trong nước cất, định mức đến 1000 ml.
Dung dịch natri hypoclorit (NaOCl): sử dụng thuốc tẩy thương mại 5%. Dung dịch bền trong hai tháng.
Dung dịch oxi hóa: trộn 100 ml dung dịch citrate với 25 ml dung dịch natri hypoclorit. Chuẩn bị dung dịch hàng ngày.
Dung dịch gốc ammoni: hòa tan 2,972 g NH4Cl khan (đã sấy khô ở 100oC) trong nước và pha loãng đến 1000 ml. 1,0 ml dung dịch này chứa 1 mg NH4+ (nồng độ 1000 mg NH4+ /l).
Dung dịch ammoni trung gian 1: 10,0 ml dung dịch ammoni gốc pha loãng đến 100 ml. 1,0 ml dung dịch này chứa 0,1 mg NH4+ (nồng độ 100 mg NH4+ /l).
Dung dịch ammoni trung gian 2: 10,0 ml dung dịch ammoni trung gian 1 pha loãng đến 100 ml. 1,0 ml dung dịch này chứa 0,01 mg NH4+ (nồng độ 10 mg NH4+ /l).
Dung dịch ammoni làm việc: 10 ml dung dịch ammoni trung gian 2 định mức 50 ml. 1,0 ml này chứa 0,002 mg NH4+ (nồng độ 2 mg NH4+ /l).
Quy trình phân tích
Lấy 25 ml mẫu cho vào bình định mức dung tích 50 ml. Thêm 1 ml dung dịch phenol, 1 ml dung dịch natri nitroprusit, 2,5 ml dung dịch oxi hóa (trộn lẫn đều dung dịch sau mỗi lần thêm thuốc thử), thêm nước cất đến vạch mức và trộn đều. Để trong bóng tối, ở nhiệt độ phòng (22 - 27oC) ít nhất 1 giờ. Đo mật độ quang ở bước sóng 640 nm với dung dịch mẫu trắng làm dung dịch so sánh. Màu ổn định trong 24 giờ.
4
Nồng độ NH + trong các mẫu được xác định dựa vào phương trình đường chuẩn có dạng y
= ax + b được xây dựng dựa trên dãy nồng độ NH4+ chuẩn có giới hạn từ 0,00 – 0,40 mg/l như bảng 12.
Thành phần và nồng độ các dung dịch xây dựng đường chuẩn
1 | 2 | 3 | 4 | 5 | 6 | 7 | |
Thể tích dd ammoni làm việc (ml) | 0 | 1 | 3 | 5 | 7 | 8 | 10 |
Thể tích dd phenol (ml) | 1 | 1 | 1 | 1 | 1 | 1 | 1 |
Thể tích dd natrinitroprusit (ml) | 1 | 1 | 1 | 1 | 1 | 1 | 1 |
Thể tích dd oxi hóa (ml) | 2,5 | 2,5 | 2,5 | 2,5 | 2,5 | 2,5 | 2, 5 |
Thể tích nước cất (ml) | Vừa đủ 50 ml | ||||||
Nồng độ ammoni (mg NH4+/l) | 0,00 | 0,04 | 0,12 | 0,2 | 0,28 | 0,32 | 0, 4 |
Cách xác định nồng độ ammonia trong các mẫu chuẩn được tiến hành như trên.
Phương pháp phân tích nitrite ( phương pháp NATHYLAMINE)
Dung dịch EDTA: hòa tan 0,5 g Disodium Ethylendiamine Tetra Acetate Dihydrate trong nước cất và định mức đến vạch 100 ml.
Acid Sulfanilic: hòa tan 0,6 g Acid Sulfanilic trong 70 ml nước cất đã được đun nóng. Để nguội, thêm 20 ml HCl đậm đặc, pha loãng đến vạch 100 ml.
Dung dịch Napthylamin Hydrochloride: hòa tan 0,6 g 1 - Napthylamin hydrochloride trong 50 ml nước cất đã thêm 1 ml HCl đậm đặc, lắc đều và thêm nước cất đến vừa đủ 100 ml.
Chú ý: Thuốc thử có thể nhạt màu và trầm hiện sau 1 tuần, ta có thể lọc và vẫn có thể dùng được. Nên bảo quản trong tủ lạnh. Sử dụng nên cẩn thận vì thuốc thử này có độc tính, do đó tránh hút bằng miệng và tránh dính vào da.
Dung dịch đệm Sodium acetate: Hòa tan 16,4 g Sodium acetate (NaC2H3O2) khan hay 27,2 g NaC2H3O2.3H2O trong nước cất và pha loãng đến 100 ml.
Dung dịch trữ Nitrite: cân chính xác 0,3749 g NaNO2 khan, hòa tan với nước cất thành 1000 ml (1 ml = 250 µg NO2- ). Để bảo quản thêm 1ml CHCl3.
Dung dịch chuẩn trung gian (1 ml = 50 µg NO2-): Lấy chính xác 50 ml dung dịch trữ cho vào bình định mức 250 ml, pha loãng với nước cất đến vạch.
Dung dịch chuẩn (1 ml = 5µg NO2- ): Lấy chính xác 10 ml dung dịch chuẩn trung gian cho vào bình định mức 100 ml. Pha loãng với nước cất đến vạch. Hai dung dịch 6, 7 chỉ pha khi dùng.
Dung dịch Sulfat Zinic (10%): Hòa tan 100 g ZnSO4.7H2 O trong nước cất, pha loãng đến 1000 ml.
Dung dịch NaOH 6N: Hòa tan 240 g NaOH trong 500 ml nước cất và pha loãng đến 1000 ml.
Xử lý mẫu: Nếu mẫu đục hoặc màu cao, cho 1 ml dung dịch ZnSO4 (10%) vào 100 ml mẫu, khuấy đều, thêm 0,4 - 0,5 ml dung dịch NaOH để đạt pH 10,5. Khuấy đều, để yên mẫu vài phút, cợn sẽ lắng xuống đáy. Lọc hay li tâm, nếu lọc, loại bỏ 25 ml đầu tiên qua lọc.
Quy trình phân tích
Lấy 50 ml mẫu đã qua xử lý và trung hòa về pH = 7,0 cho vào các ống nessler.
Thêm vào mỗi ống nessler 1 ml dung dịch EDTA, 1 ml dung dịch acid sunfanilc. Lắc đều, pH của mẫu lúc này khoảng 1,4. Để yên 3 – 10 phút.
Thêm vào 1 ml napthylamine hydrochloride và 1 ml dung dịch đệm acetate. Lắc đều, pH của dung dịch lúc này khoảng 2 – 2,5. Để yên trong 10 – 30 phút. Đo mật độ quang học ở bước sóng 520 nm. Đọc và ghi nhận kết quả.
Nồng độ NO2- trong các mẫu được xác định dựa vào phương trình đường chuẩn có dạng y
= ax + b được xây dựng dựa trên dãy nồng độ NO2- chuẩn có giới hạn từ 0,00 – 0,35 mg/l như bảng 13.
Thành phần và nồng độ các dung dịch xây dựng đường chuẩn
0 | 0,2 | 0,5 | 1 | 1,5 | 2 | 2,5 | 3 | 3,5 | |
ml nước cất thêm vào | 50 | 49,8 | 49,5 | 49 | 48,5 | 48 | 47,5 | 47 | 46,5 |
Số µg NO2- | 0 | 1 | 2,5 | 5 | 7,5 | 10 | 12,5 | 15 | 17,5 |
mg/l NO2- | 0 | 0,02 | 0,05 | 0,1 | 0,15 | 0,2 | 0,25 | 0,3 | 0,35 |
Cách xác định nồng độ NO2- trong các mẫu chuẩn được thực hiện như quy trình trên.
Phương pháp phân tích nitrate ( phương pháp SALICYLATE)
Dung dịch A: Sodium salycilate 0,5%: hòa tan 0,5 g Sodium salycilate vào nước cất và định mức đến 100 ml.
Dung dịch B: Sulphuric acid 96%.
Dung dịch C: sodium hydroxide 10 mol/l: hòa tan 400g NaOH trong nước cất và định mức đến vạch 100 ml.
Dung dịch chuẩn: Potassium nitrate: 100 mg/l (0,1631 g KNO3 đã sấy khô ở 105oC, sau đó hòa tan trong nước cất và định mức đến 1000 ml).
Quy trình thực hiện
Lấy 10 ml mẫu đã qua xử lý, cho vào hũ thủy tinh, thêm 1 ml dung dịch sodium salycilate 1%, lắc đều. Cô cạn dung dịch.
Sau khi làm lạnh, thêm 1 ml dung dịch acid sunfuric 96%, chờ 10 phút.
Thêm 7 ml dung dịch NaOH 10 mol/l vào các hũ thủy tinh trên, để nguội, thêm nước cất cho đủ 50 ml. Lắc đều, để yên trong 10 phút cho màu ổn định.
Đo mật độ quang học ở bước sóng 410 nm. Đọc và ghi nhận kết quả.
Hàm lượng NO3- trong mẫu được xác định dựa vào phương trình đường chuẩn có dạng y = ax + b được xây dựng dựa trên dãy nồng độ NO3- chuẩn có giới hạn từ 0,00 – 0,35 mg/l như bảng 14.
Thành phần và nồng độ các dung dịch xây dựng đường chuẩn.
1 | 2 | 3 | 4 | 5 | 6 | 7 | 8 | |
Thể tích dung dịch KNO3 100 mg/l (ml) | 0,0 | 1,0 | 2,0 | 3,0 | 4,0 | 5,0 | 7,5 | 10,0 |
Thể tích dung dịch A (ml) | 1 | 1 | 1 | 1 | 1 | 1 | 1 | 1 |
Thể tích dung dịch B (ml) | 1 | 1 | 1 | 1 | 1 | 1 | 1 | 1 |
Thể tích dung dịch C (ml) | 7 | 7 | 7 | 7 | 7 | 7 | 7 | 7 |
Thể tích nước cất (ml) | Vừa đủ 50 ml | |||||||
Nồng độ mẫu chuẩn (mg/l) | 0,0 | 2,0 | 4,0 | 6,0 | 8,0 | 10,0 | 15,0 | 20,0 |
Cách xác định hàm lượng NO3- trong các mẫu chuẩn được thực hiện như quy trình trên
1.6 Khảo sát đặc tính chuyển hóa ammonia, nitrite, nitrate và chịu mặn của các dòng vi khuẩn
Bảng 1.11 Định tính khả năng chuyển hóa nitrite và nitrate của các dòng vi khuẩn AOB
Dòng vi khuẩn | Chuyển hóa NO2- | Chuyển hóa NO3- |
Bacillus sp. B5 | + | + | |
2 | Bacillus sp. B31 | + | - |
3 | Bacillus sp. B58 | - | - |
4 | Bacillus sp. B68 | + | - |
5 | Bacillus sp. B74 | + | - |
6 | Bacillus licheniformis B85 | + | + |
7 | Pseudomonas stutzeri KL15 | + | + |
8 | Sphingoacterium multivorum KL26 | - | - |
9 | Providencia stuartii KL30 | + | - |
10 | Alcaligenes faecalis KL33 | + | + |
(+): phản ứng dương tính; (–): phản ứng âm tính.
Bảng 1.12 Định tính khả năng chuyển hóa ammonia và nitrate của các dòng vi khuẩn NOB
Dòng vi khuẩn | Chuyển hóa NH4+ | Chuyển hóa NO3- | |
1 | Chryseobacterium gleum CKT | + | + |
2 | Chryseobacterium gleum C2/1 | + | - |
3 | Stenotrophomonas pavanii C2/2 | + | - |
4 | Stenotrophomonas maltophilia C3/1 | + | - |
5 | Stenotrophomonas pavanii C4/2 | + | - |
6 | Stenotrophomonas pavanii TKT | + | - |
7 | Stenotrophomonas maltophilia T1 | + | + |
8 | Stenotrophomonas pavanii T2/2 | + | + |
9 | Delftia lacustris T3/1 | + | + |
10 | Acinetobacter junii T4/1 | + | - |
11 | Rhodococcus rhodochrous T9 | + | + |
(+): phản ứng dương tính; (–): phản ứng âm tính..
Bảng 1.13 Hiệu suất chuyển hóa NO2- của 4 dòng vi khuẩn AOB
Dòng vi khuẩn | Hiệu suất chuyển hóa NO2 của 4 dòng vi khuẩn | ||||
ST T | 1 ngày | 2 ngày | 3 ngày | 4 ngày | |
1 | Bacillus sp. B5 | 29,33a ± 0,09 | 40,63a ± 0,16 | 90,97c ± 0,22 | 92,58c ± 0,01 |
2 | Bacillus licheniformis B85 | 17,98b ± 0,01 | 36,45b± 0,09 | 94,98a± 0,11 | 96,97b ± 0,13 |
3 | Pseudomonas stutzeri KL15 | 5,46d ± 0,03 | 24,02c± 0,08 | 94,18b± 0,08 | 99,06a± 0,02 |
4 | Alcaligenes faecalis KL33 | 8,76c ± 0,12 | 26,25d± 0,06 | 87,36d ± 0,09 | 90,53d± 0,07 |
Trong cùng một cột, các giá trị có ký tự theo sau giống nhau không có sự khác biệt về mặt thống kê (P < 0,05).
Bảng 1.14 Hiệu suất chuyển hóa NO3- của 4 dòng vi khuẩn AOB và 4 dòng NOB
Hiệu suất chuyển hóa NO3- 8 dòng vi khuẩn.
1 ngày | 2 ngày | 3 ngày | 4 ngày | ||
1 Bacillus sp. B5 | 7,32g ± 0,07 | 40,63c± 0,05 | 63,48d ±0,05 | 63,87f± 0,05 | |
2 Bacillus licheniformis B85 | 12,46d ± 0,17 | 43,87b ±0,09 | 89,36b ±0,12 | 89,63b± 0,14 | |
3 Pseudomonas stutzeri KL15 | 9,67f ± 0,1 | 44,35b ±0,25 | 98,07a ±0,04 | 98,02a± 0,01 | |
4 Alcaligenes faecalis KL33 5 Chryseobacterium gleum CKT 6 Stenotrophomonas maltophilia | T1 | 16,25b± 0,02 6,59h ± 0,05 10,43e± 0,04 | 36,45e ±0,02 28,37g ±0,12 37,46d ±0,22 | 51,32f± 0,01 42,61g± 0,08 63,42d ±0,07 | 52,12g± 0,02 45,36h ±0,04 64,29e± 0,12 |
STT Dòng vi khuẩn
Stenotrophomonas pavanii T2/2 | 13,84c ±0,03 | 32,78f± 0,1 | 60,29e ±0,06 | 65,45d± 0,1 | |
8 | Rhodococcus rhodochrous T9 | 17,41a ±0,02 | 57,20a± 0,07 | 80,97c ±0,13 | 81,24c± 0,06 |
Trong cùng một cột, các giá trị có ký tự theo sau giống nhau không có sự khác biệt về mặt thống kê (P < 0,05).
Bảng 1.15 Hiệu suất chuyển hóa NH4+ của 4 dòng vi khuẩn NOB
Dòng vi khuẩn | Hiệu suất chuyển hóa NH4+ của 4 dòng vi khuẩn | ||||||
STT | 1 ngày | 2 ngày | 3 ngày | 4 ngày | 5 ngày | 6 ngày | |
1 | C. gleum CKT | 11,37d ± 0,06 | 25,68d ± 0,08 | 37,88c ± 0,01 | 42,68d ± 0,15 | 63,39c ± 0,1 | 64,01c ± 0,11 |
2 | S.maltophilia T1 | 13,153c ± 0,12 | 26,52c ± 0,05 | 35,86d ± 0,05 | 46,81c ± 0,04 | 60,61d ± 0,12 | 59,12d ± 0,07 |
3 | S. pavanii T2/2 | 16,23b ±0,12 | 27,48d ±0,17 | 38,39b ±0,02 | 47,92b ±0,04 | 70,23b ± 0,1 | 69,34b ±0,02 |
4 | 28,62a ± 0,18 | 32,32a ± 0,02 | 56,87a ± 0,06 | 80,93a ± 0,02 | 86,21a ± 0,02 | 85,87a ± 0,07 | |
R.rhodochrous T9 |
Trong cùng một cột, các giá trị có ký tự theo sau giống nhau không có sự khác biệt về mặt thống kê (P < 0,05).
Bảng 1.16 Khảo sát khả năng chịu mặn của các dòng vi khuẩn AOB
OD600nm | ||||||||
STT | Dòng vi khuẩn | Nồng độ muối NaCl (%) | ||||||
2% | 3% | 4% | 5% | 6% | 7% | |||
1 | Bacillus sp. B5 | 0,99±0,01 | 0,99±0,01 | 0,91±0,03 | 0,78±0,02 | 0,58±0,01 | 0,32±0,01 | |
2 | Bacillus licheniformis B85 | 0,95±0,01 | 0,95±0,01 | 0,86±0,02 | 0,69±0,03 | 0,42±0,04 | ||
0,27±0,02 | ||||||||
3 | Pseudomonas stutzeri KL15 | 0,89±0,01 | 0,89±0,01 | 0,8±0,03 | 0,52±0,03 | 0,36±0,03 | ||
0,15±0,02 | ||||||||
4 | Alcaligenes faecalis KL33 | 0,92±0,01 | 0,92±0,01 | 0,75±0,03 | 0,67±0,03 | 0,34±0,03 | ||
0,13±0,01 | ||||||||
Trong cùng một cột, các giá trị có ký tự theo sau giống nhau không có sự khác biệt về mặt thống kê (P < 0,05).
Bảng 1.17 Khảo sát khả năng chịu mặn của các dòng vi khuẩn NOB
OD600nm | |||||||
STT | Dòng vi khuẩn | Nồng độ muối NaCl (%) | |||||
2% | 3% | 4% | 5% | 6% | 7% | ||
1 | Chryseobacterium gleum CKT | 0,82±0,03 | 0,82±0,03 | 0,71±0,02 | 0,64±0,03 | 0,37±0,02 | 0,08±0,01 |
2 | Stenotrophomonas maltophilia T1 | 0,98±0,01 | 0,98±0,01 | 0,76±0,03 | 0,58±0,04 | 0,39±0,02 | 0,26±0,04 |
3 | Stenotrophomonas pavanii T2/2 | 0,84±0,03 | 0,84±0,03 | 0,69±0,03 | 0,48±0,01 | 0,14±0,02 | 0,07±0,02 |
4 | Rhodococcus rhodochrous T9 | 0,91±0,02 | 0,91±0,02 | 0,84±0,02 | 0,61±0,05 | 0,25±0,03 | 0,11±0,02 |
Trong cùng một cột, các giá trị có ký tự theo sau giống nhau không có sự khác biệt về mặt thống kê (P < 0,05).






